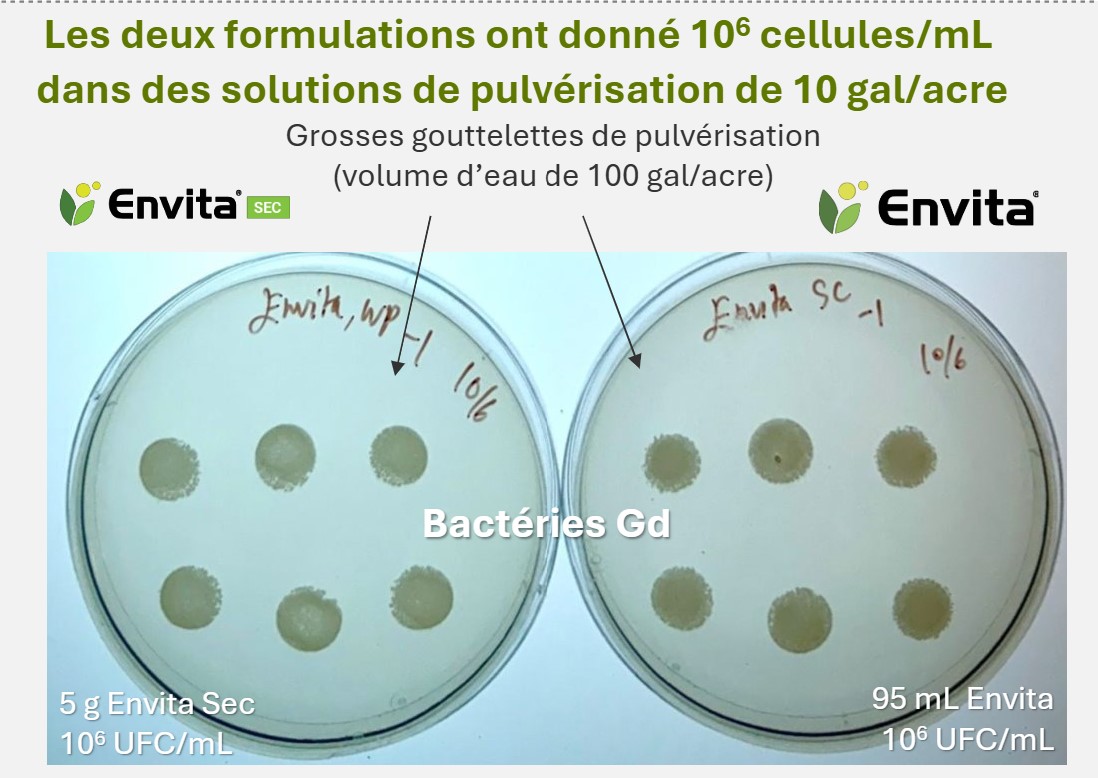
Envita Sec

L’utilisation de l’azote limite-t-elle vos cultures?
17 oct 2025
Qu’est-ce qu’Envita Sec?
Envita® Sec, produit biologique fixateur d’azote le plus recherché, vous permet de devancer les besoins en azote de vos plantes en permettant que la fixation de l’azote se produise dans leurs feuilles. Envita est systémique, ce qui garantit que cet élément nutritif essentiel est disponible au bon endroit et au bon moment, tout au long de la saison.
Offert exclusivement par Syngenta au Canada, Envita Sec contient la bactérie vivante Gluconacetobacter diazotrophicus (Gd), une bactérie naturelle de qualité alimentaire qui permet un mode unique de fixation de l’azote dans une grande variété de cultures.
Après application, les bactéries forment une relation symbiotique avec la plante hôte et finissent par se répliquer et se propager dans les cellules végétales. Elles commencent alors à fixer l’azote de l’air et continuent à le faire tout au long de la saison, ce qui offre à la plante hôte une source complémentaire d’azote depuis l’application jusqu’à la récolte.
Résultats des essais
De 2022 à 2024, Syngenta s’est associée à des producteurs de pommes de terre d’un peu partout au Canada pour tester le produit biologique fixateur d’azote Envita, en formulation liquide et sèche. Ils l’ont ajouté à leurs programmes existants de fertilisation, d’irrigation et de lutte antiparasitaire, sans modifier le reste de ces programmes.
Envita Sec est équivalent à l’ancienne formulation liquide Envita, ayant la même matière active, avec la même charge et les mêmes performances.
Dans les essais où les deux formulations ont été comparées, aucune différence notable n’a été constatée en matière de performances.
▄ Envita liquide
▄ Envita Sec
Résultat : 83 % des essais ont montré une réponse de rendement positive après une application d’Envita liquide ou d’Envita Sec, avec une amélioration moyenne du rendement de 32 quintaux/acre par rapport au témoin non traité2*.
* Les chiffres relatifs à la réponse de rendement et à l’amélioration moyenne du rendement ont été déterminés en combinant les données de rendement des cultures traitées avec Envita liquide et celles des cultures traitées avec Envita Sec.
Optimisez votre application d’Envita Sec grâce à ces conseils :
Appliquez le produit soit tôt le matin, lorsque les stomates sont ouverts mais avant que le temps de séchage s’accélère, soit plus tard dans l’après-midi, une fois que la chaleur de la journée est passée. Évitez les applications en soirée, lorsque les stomates sont fermés.
Il est préférable d’appliquer Envita Sec seul, avec un agent tensioactif non ionique à raison de 0,1 % v/v.
- Si, par ailleurs, vous décidez de mélanger Envita Sec en réservoir, tenez compte des points suivants : Jusqu’à ce qu’un produit d’association en réservoir soit officiellement testé au Canada par le fabricant (Azotic), les producteurs agricoles devraient présumer que tout produit d’association en réservoir a le potentiel d’avoir un effet néfaste sur Gluconacetobacter diazotrophicus (« Gd », la matière active d’Envita Sec). Les tests effectués jusqu’à présent ont montré que certaines formulations, y compris de glyphosate, sont nocives pour Gd dans le mélange au bout d’une heure.
- Si, par ailleurs, vous décidez de mélanger Envita Sec en réservoir, suivez alors les meilleures pratiques de gestion recommandées par Azotic :
- Entreposez le produit dans un endroit frais et sec.
- Il est préférable d’appliquer Envita Sec seul, avec un agent tensioactif non ionique.
- Si vous l’appliquez dans un mélange en réservoir, veuillez suivre les lignes directrices d’Azotic pour les produits d’association en réservoir et assurez-vous d’ajouter Envita Sec en dernier dans le réservoir :
- Utilisez de forts volumes d’eau. Volume minimal d’eau : 10 à 15 gal/acre.
- Températures optimales pour l’application :
Humidité relative de plus de 80 % : 10 à 30 °C
En dessous de 80 % d’humidité relative : 10 à 25 °C
Tous les produits ne peuvent pas nécessairement être mélangés en réservoir avec Envita Sec. Pour de plus amples renseignements, visitez www.syngenta.ca/fr/productsdetail/envita-dry#tank-mix.
Point clé à retenir
L’équipe de Syngenta continue de mener chaque année des essais chez des producteurs, afin d’enrichir notre expérience et nos connaissances agronomiques dans le domaine des bioproduits. À ce jour, les producteurs ont utilisé Envita Sec en complément de leur programme de fertilisation standard, le laissant répondre aux besoins en azote des cultures tout au long de la saison de croissance, lorsque les engrais azotés standards peuvent ne pas être disponibles.
Vous cherchez des renseignements supplémentaires ou vous vous demandez comment Envita se comporte dans d’autres cultures horticoles? Parlez-en à votre représentant ou au détaillant Syngenta de votre localité.
1 Source de la photo : Essais réalisés par des tiers sur le nombre de cellules Envita à un volume d’eau de 10 gallons par acre (n = 1). Source de la figure : Essais menés chez des producteurs (n = 12) en 2023 et 2024, au cours desquels les formulations liquide et sèche d’Envita ont été évaluées dans le même champ. Canola (n = 2), maïs (n = 2), pommes de terre (n = 3), blé de printemps (n = 3), blé d’hiver (n = 2), haricots blancs (n = 1), soya (n = 2). Les évaluations de performance sont basées sur des essais internes, des observations de terrain et/ou des informations publiques. Autant que possible, on devrait consulter des données recueillies sur plusieurs sites et pendant plusieurs années. Les résultats individuels peuvent varier en fonction des conditions locales de croissance, de sol et de météo. Toujours lire l’étiquette et s’y conformer. Les marques de commerce sont la propriété de leurs titulaires respectifs.
2 Source : Essais menés chez des producteurs en AB, SK, MB, ON, QC et PE en 2022-2024. Envita liquide (n = 58), Envita Sec (n = 2), les deux formulations (n = 3). Gluconacetobacter diazotrophicus a été appliqué à raison de 95 mL/acre ou de 5 g/acre. Envita Sec fournit la même quantité de matière active par hectare qu’Envita liquide. Rendement déterminé par 3 récoltes de 10 pi ou par la distance nécessaire pour remplir un camion lors de la récolte. Les chiffres relatifs à la réponse de rendement et à l’amélioration moyenne du rendement ont été déterminés en combinant les données de rendement des cultures traitées avec Envita liquide et celles des cultures traitées avec Envita Sec*.
Les évaluations de performance sont basées sur des essais internes, des observations de terrain et/ou des informations publiques. Autant que possible, on devrait consulter des données recueillies sur plusieurs sites et pendant plusieurs années. Les résultats individuels peuvent varier en fonction des conditions locales de croissance, de sol et de météo.
Toujours lire l’étiquette et s’y conformer. Le logo Syngenta est une marque de commerce d’une société du groupe Syngenta. Envita® est une marque déposée d’Azotic Technologies limitée, utilisée sous licence.